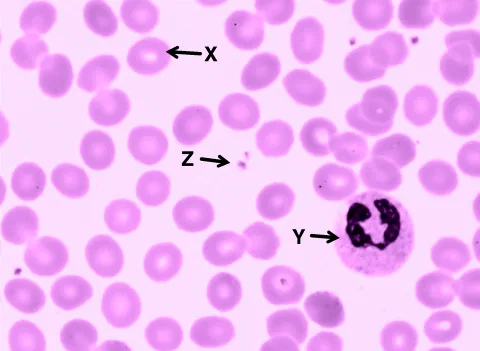
img
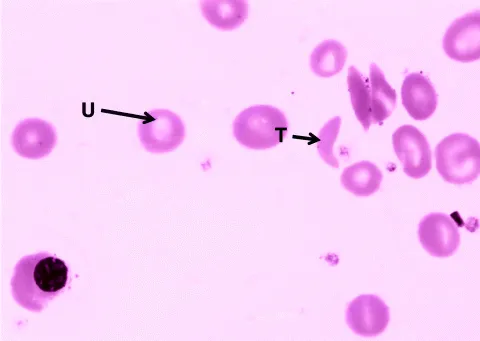
img
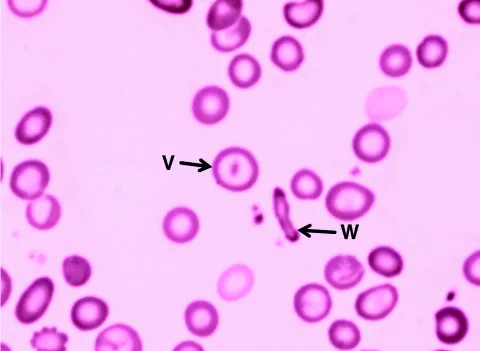
img

Featuring over 200 questions on key topics in medicine, each question is set around an image or investigation, such as an X-ray, CT scan, or blood film, and tests identification and interpretation of the data provided. Thorough explanation of the correct and incorrect answers helps you learn from mistakes.ย The questions reflect current exam question style and incorporate high quality images, many of which are annotated, and are presented in full colour throughout.
Data Interpretation for Medical Finals will help build the confidence of all medical students, and Foundation Doctors, as it encourages application of investigation results to clinical decision making.